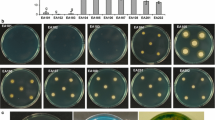

Abstract
Arsenic naturally occurs in the earth’s crust and can be introduced in the environment by human activities. Agricultural practices in arsenic-contaminated environments pose a threat to human health. The contamination of crops contributes to the metalloid’s introduction in the food chain. This study aims to test the hypotheses that the inoculation of a hyperaccumulator rhizobacterial strain, Ochrobactrum tritici As5, to the rhizosphere of rice plants reduces the arsenic presence inside the tissue of the rice plants and reduces the inhibitory effect of the metalloid on the plant’s growth parameters. Inoculation of the hyperaccumulating strain O. tritici As5 showed the lowest concentration of arsenic in the plant’s tissue (2.6 fold lower than sterile plants), compared to the unmodified type O. tritici SCII24 and sterile rice plants. The inoculation of the type strain SCII24 also led to a decrease in arsenic concentration in the plant tissue compared with sterile plants (1.6 fold lower than sterile plants). The difference in arsenic presence in shoots was smaller among treatment groups than in the roots, showing a similar trend. The inoculation of the hyperaccumulator As5 strain alleviated some of the toxic effects of arsenic on shoot growth compared to inoculation of the unmodified type strain. All these findings together, contribute to our understanding of the interplay between arsenic pollution, plants and their rhizobacteria, especially the role of bioaccumulation of metal(oids) by rhizobacteria, and provide important information on the prevention of arsenic uptake by crops and the development of phytostabilizers.
Graphic abstract

Similar content being viewed by others
Explore related subjects
Discover the latest articles, news and stories from top researchers in related subjects.Avoid common mistakes on your manuscript.
Introduction
Thousands of people around the world face the adverse health effects of arsenic in their environment (Mandal and Suzuki 2002). Arsenic naturally occurs in the earth’s crust and but can also be introduced in the environmentthe environment by through different human activities, such as the use of pesticides and chemical fertilizers, mining extraction procedures and industrial wastes production (Kofroňová et al. 2018). Therefore, arsenic can be found in soils, which could easily enter into the food chain. In rice and other vegetables it is present for 85–95% as inorganic species, compared to 65–75% in many other food products (Mandal and Suzuki 2002). The accumulation of arsenic in crops constitutes a serious threat to public health (Kofroňová et al. 2018), since long term exposure to elevated arsenic levels is related to various kinds of cancers, skin lesions, pulmonary disease, peripheral vascular disease, arterial hypertension, diabetes mellitus, neuropathy and cardiovascular diseases (Flanagan et al. 2012). For example, such arsenic contamination in crops is found in some sites of China, where around 50% of the total arsenic intake is due to contaminated rice (Zhao et al. 2010).
Although arsenic mainly occurs as the arsenite or arsenate speciation, the arsenite species is more mobile and more toxic than arsenate (Tsai et al. 2009). Arsenite, As(III), is present in slightly reducing conditions, such as rice paddy fields and arsenate, As(V), is present in oxidizing conditions (Kofroňová et al 2018). In general, As(V) is taken up by the plant via phosphate transporters, whereas arsenite and methylated arsenic is taken up by the nodulin 26-like intrinsic protein transporters (NIPs) (Briat 2010).
Plants can exudate secondary metabolites of the contaminants that attract and allow the growth of specific endophytic, rhizoplane and rhizosphere bacterial communities that can further metabolize the exudates (Zhuang et al. 2007). The rhizoplane and rhizosphere soil of the plants offer a protected environment for bacteria that would normally not reach a stable population in the microbial communities in absence of the plant (Zhuang et al. 2007). Additionally, the microbial communities in the rhizosphere soils and rhizoplane in heavy metal contaminated areas are able to withstand high concentrations of heavy metals (Dell’Amico et al. 2005). Rhizobacteria can influence the relation between the metal contaminant and the plant by the production of siderophores that can increase with heavy-metal presence, 1-aminocyclopropane-1-carboxylate (ACC) deaminase, an ethylene stress reducing hormone, growth promoting hormones such as indole-3-acetic acid (Zhuang et al. 2007; Dell’Amico et al. 2005), a biofilm and exopolysaccharides (Tiwari and Lata 2018). Rhizobacteria can alter plant metabolism by changing their physiology through ion and nutrients uptake, nitrogen fixation (Zhuang et al. 2007) or intra-cellular sequestration (Ma et al. 2011). Additionally, they can decrease the mobility of anions and metal ions extracellularly in the rhizosphere by promoting extra-cellular sequestration of metals in insoluble phosphate particles (Francisco et al. 2011), or through detoxification mechanisms of the metal contaminant, which may change solubility through the modification of metal oxidation state (Ma et al. 2011). The high surface to volume ratio of bacterial cells enables a high uptake of metal either actively or passively (Ma et al. 2011). Metals can be coordinated by anionic compounds such as amine, hydroxyl, amide, sulfhydryl and carboxyl functional groups that cause sequestration (Ma et al. 2011). Besides reducing the mobility of metals, the rhizobacteria can enhance the bioavailability of the metals via the production of organic acids and siderophores (Ma et al. 2011).
Two possibilities of dealing with arsenic contamination in crops, are (1) the use of phytoremediation to clean the ground of arsenic, or (2) the prevention of arsenic influx in the harvested plant tissue (Kofroňová et al. 2018). Most mitigation strategies, like management of arsenic contaminated water to crops, silicon fertilizers, selective breeding, genetic engineering and phytoextraction (Zhao et al. 2010), fall under these two categories. Although some reported studies focus on the inoculation of bacteria to enhance phytostabilization of harmful components (Ma et al. 2011), few studies have focussed on the use of bacterial inoculants to prevent metal uptake by plants. Examples of such studies include: uptake of aluminum and zinc in soybean (Bilal et al. 2018), nickel and cadmium in tomato plants (Madhaiyan et al. 2007), cadmium in sunflowers (Shahabivand et al. 2017) and arsenate in Acacia farnesiana (Alcantara-Martinez et al, 2018). To our knowledge, no studies were performed on decreasing arsenic concentrations inside the crops by using endophytes and/or rhizobacteria.
In the present study, the focus was the second strategy, preventing the arsenic from entering in the harvested plant tissue and keeping the metalloid within the rhizosphere. For this purpose, we used a rhizobacterium, an unmodified type strain Ochrobactrum tritici SCII24T, and a mutated arsenic accumulating version with defective ArsB and Acr3p pumps: strain O. tritici As5 (Sousa et al. 2015).
To realize the feasibility of plant–bacterium consortium for use in metal contaminants phytostabilization strategies, preventing metal translocation to the harvestable parts of the plant, it is necessary to find the effects of metal accumulation by these rhizobacteria on the plant. It is expected that (1) the bacterial strain able to accumulate a higher amount of arsenic inside the cells (with non-functional arsenite efflux pumps) will reduce the arsenite uptake by Oryza sativa more than the strain with a lower accumulating potential (carrying the operational genes) and (2) the arsenite accumulating bacterial strain used in this study, O. tritici As5, will lead to an increased plant growth in presence of arsenic. The aims of the present study are (1) to determine if metal accumulation by rhizobacteria decreases plant metal uptake and growth development disturbance and (2) the development of a bacterium–plant interaction, able to reduce arsenic uptake by the rice plant.
Materials and methods
Bacterial strains and plant varieties
Ochrobactrum tritici SCII24T (strain LMG 18957T from LMG Culture Collection, Laboratorium voor Microbiologie, Universiteit Gent) is a highly As-resistant bacterium, with two previously described arsenic resistance operons, ars1 and ars2 (Branco et al. 2008). In this organism, the two ars operons (ars1 and ars2) previously characterized comprise a large number of genes related to the bacterial ability to resist up to 50 mM arsenic (Branco et al. 2008). Among these genes, arsB and Acr3_1 encode two different arsenite efflux pumps. Double mutation of arsB and Acr3_1 genes resulted in the strain O. tritici As5 (UCCCB, the Bacterial Culture Collection of the University of Coimbra), with remarkably low As(III) resistance, up to 1 mM (Sousa et al. 2015) and an increased arsenic accumulation ability. In the presence of 1 mM As(III), O. tritici As5 accumulates concentration up to 17 ng As/mg protein. The type strain O. tritici SCII24, and the modified strain O. tritici As5 were used for this study. Both strains were able to grow on surfaces, while retaining their ability to accumulate arsenic (Branco et al. 2016).
The rice plants, Oryza sativa japonica, a local variety (Aríete), were obtained as capped seeds from the Mondego river bank. The Mondego river bank is one of the major rice producing areas of Portugal, spanning an area of 6000 ha, and the most common “Carolino” varieties that are grown in Portugal are “Aríete” and “Euro” (Fraga et al. 2019).
Seed sterilization and germination
The seeds were uncapped and sterilized. Briefly, an initial washing step with 70% ethanol for 1 min was performed, followed by a second washing step with 2.5% sodium hypochlorite for 15 min and two washing steps for 15 min with sodium hypochlorite:desinfestation solutions in the proportions of 2.3:1 and 1:1 similar to the protocol of Hurek et al. (1994). The disinfestation solution consisted of 1 g/L of Na3CO3, 30 g/L of NaCl and 1.5 g/L of NaOH (Hurek et al. 1994). The seeds were placed on water-agar plates with 8 g/L agar and 500 mg/L of yeast extract, and incubated for 72 to 120 h at 25 °C. The germination rate of the plants was around 80% (Fig. 1; Supplementary Material) and the non-germinated seeds were discarded.
Experimental design
A total of 228 rice plant seeds were grown in sterile conditions. The plants were divided in six groups (Table 1). The first group of plants served as a control without any bacterial strain nor arsenic in the medium. The second group of plants has been exposed to 25 µM of arsenite. The third group of plants was not incubated with arsenic but was inoculated with bacterial strains, with the modified strain As5 or with the native strain SCII24 in experiment 1 or experiment 2, respectively. The fourth group comprises the plants inocculated with As5 strain and exposed to 25 µM of arsenite in both experiments. The fifth plant group was just used in experiment 1 and corresponds to plants incubated with 40 µM of arsenite and in the presence of strain As5. The sixth group was unique to experiment 2 and contained the plants assayed with SCII24 strain and in presence of 25 µM arsenite.
Growth conditions
The germinated seeds were transferred to sterile glass tubes containing 10 mL semi-solid Hoagland medium (Hoagland and Arnon 1950) with 2 mM ammonium nitrate and capped with a cotton plug. The seedlings were kept in for periods of 10 to 14 h of dark to light (2000 lx) during 7 days at 25 °C. All the plants were transferred to 10 mL new semi-solid medium, with or without the bacterial strain, in sterile tubes for 3 days at similar growth conditions. Plants with bacteria were inoculated by either strains O. tritici As5 or SCII24, grown for 24 h on Lysogeny Broth (LB) medium at 37 °C and 130 rpm (Agitorb 200, Aralab, Portugal), at a final concentration of 0.1 OD600 in 10 mL plant medium. Finally, plants were transferred to new tubes containing sodium arsenite, in the following manner: the roots of the plants were washed with sterile ultra-pure water and the plants were transferred to clean sterile glass tubes with 10 mL semi-solid medium with 2 mM ammonium nitrate and containing 0 µM, 25 µM or 40 µM sodium arsenite. After the first period of growth and before addition of arsenic the fresh weight, stem length, length of longest root and the number of roots of the plants, were measured. At the end of the assays (the final phase with arsenic) the plants were removed from the tubes and left on dry paper to remove the outside liquid. The plants from the second experiment were divided in root and upper part of the plant. All the plants had again their fresh weight, length of longest root, length of stem and number of roots measured. The plants were left in an open tube, covered with a sheet of paper at 50 °C during 14 days. Then, the weight of the dried plants was measured.
Molecular techniques
At the end of the assays the presence of the bacterial strain was confirmed by PCR amplification for the strain O. tritici As5, with Scanning Electron Microscopy (SEM) and plating for the type strain O. tritici SCII24. For PCR amplification, DNA was extracted using the soil DNA extraction kit, E.Z.N.A.® Soil DNA kit (Omega Bio‐Tek, Inc., Norcross, GA, USA) and the primers used were specific for the gentamycin resistance gene present in the strain O. tritici As5: Gmf: GAGCTCGACGCACACCGTGGAAA and Gmr: GAGCTCGCGGCGTTGTGACAATTT (My cycler©, Biorad, Hercules, USA; transilluminator, Biorad, Hercules, USA). Thefresh samples of the other plants were fixated, sputtered with a 5 nm gold layer and analysed with SEM microscopy (model XL 30 equipped with a tungsten filament, Philips). The medium of five plants of each group was plated at 25 °C on LB medium to check for contamination.
Arsenic analysis
In order to determine the total arsenic present in each sample, nitric acid (5%) and hydrofluoric acid (1%) were added to the plant samples to a total volume of 1.5 mL for digestion and metal solubilization. The plant-acid samples were left at 30 °C during 7 days, centrifuged at 12,000 rpm for 10 min and 250 μL of supernatant was diluted in 5 mL acid mixture to result in 2% nitric acid and 0.1% fluoric acid. The arsenic measurements were performed by inductively coupled plasma mass spectrometer (ICP-MS) (iCAP Q ICP-MS Thermo Fisher Scientific Inc., Bremen, Germany). Besides measuring the total arsenic in all plants individually, samples were taken for shoot and root tissue separately pooled into units of 3, during experiment 2.
Data analysis
The data was analysed in the vegan, ggplot2, sm and ART packages in R, using an NMDS test (vegan package Oksanen et al. 2018), ANCOVA (sm package; Bowman and Azzalini 2018) contrasts of estimated marginal means (emmeans package; Lenth 2019) or Shapiro–Wilk and Kruskal–Wallis tests (R Core Team 2018 + ggplot2 package; Wickham 2016 for graphs). The proportion of arsenic taken up by the plants from the medium was tested against the fresh weight and length growth of the plants taking into account the covariance of the different plant groups via an Aligned Rank Transform (ART) for Nonparametric Factorial Analysis (ARTool package; Villacorta 2015). The small effect of experiment variance (4.1% of total variance) was taken out of the treatment group comparisons by normalizing for the total average all groups in the experiment. The growth parameter shoot growth was taken as a covariate in analysing the effect of treatment group on plant arsenic uptake.
Results
Bacterial inoculation
The presence of strain O. tritici As5 in the plant tissues or close to the roots at the end of the assay was confirmed since the plant material showed positive bands in PCR for the primers, specific for the gentamycin resistance gene. Additionally, SEM photographies showed a layer of bacterial cells at the root surface of the plants inoculated with the strains As5 (Fig. 1c–f) and plating confirmed the presence of the strain SCII24 in the plant medium. Of all the variables measured, the variance was found to be 4.1% due to the series of experiments (1 and 2) and this variance was taken out of the plant treatment group comparisons by normalizing for the average of a variable per experimental group.
A scanning electron microscopy (SEM) image of the root tissue shows the colonization of the root’s surface by strain O. tritici As5. a root of a non-inoculated rice plant. b the root of a non-inoculated rice plant at a finer resolution. c–f Cells of the O.tritici As5 strain (indicated with a white arrow) localized between the mucigel and the epidermis formed a layer that may be a biofilm
Morphological parameters
The shoot growth and fresh weight of the plants were the highest in the control group without arsenic and inoculated bacterial strain: 0.11 ± 0.01 g fresh weight; (± 95% CI; ANOVA, Tukey test; p < 0.01). The lowest weight and shoot growth was observed in the groups with bacterial strains and the groups with both, inoculated bacterial strains and arsenite presence (Table 2; Supplementary Materials). The negative effect of bacterial inoculation and the presence of both sodium arsenite and inoculated bacteria was not shown to be different in terms of the fresh weight (group 4: group 3; 0.109 g: 0.107 g; p = 0.172). Despite this, in experiment 1 with the strain O. tritici As5 inoculated, the shoot growth was bigger in the groups with arsenite than the groups without the metalloid (p < 0.05).
The plant treatment group without bacterial strains had significantly the highest plant shoot growth and fresh weight in experiment 1 and 2 (p < 0.05; Tukey post-hoc test), except for the difference in freshweight between the group with elevated arsenic (5) in experiment 1 and the group with only 25 µM arsenic, which was not significantly different. No significant differences were found in plant growth and fresh weight between plant treatment groups besides the control, suggesting a similar negative effect of inoculation with the bacterial strain or the addition of arsenic or both (Table S1; Supplementary Material). There was a some small difference between experiments (4.1% of total variance) and the plant treatment groups were normalized for the average of their experiment. The morphological parameters of the rice plants’ samples tended to either increase their shoot length or focus on their number of roots and rootlength (Fig. 2). The morphological parameters showed a high correlation among them and therefore represented the growth parameters of the plants similarly (Spearman’s rank order correlation p < 0.001). Of these parameters, shoot length growth and fresh weight were chosen as the most indicative of the plant’s growth parameters. Shoot growth explained a fair amount of the variance among groups from the first NMDS axes (Fig. 2). The fresh weight was considered an important factor of the physiological status and showed a similar trend as with the number of roots and root length (Fig. 2). A linear model that predicted the relative increase in shoot length per experiment with bacterial inoculation, arsenic concentration and their interaction showed a significant interaction between the inoculation of the bacterial strain and the arsenic concentration (ANCOVA; p = 0.00065). The linear trend for both shoot growth and fresh weight was different from As5-inoculated plants and non-inoculated plants (p = 0.0004; p = 0.035). The trend in shoot growth was different for the plants that were inoculated with the As5 strain and the SCII24 type strain in the presence of arsenic (trend analysis of estimated marginal means; p = 0.024). In presence of 25 µM arsenic the plant length showed a bigger decrease for the SCII24 strain than the plants inoculated with the As5 strain (Fig. S2; Supplementary Material). After the final assay, several plants showed withering at the top of their leaves. The withering may be related to root and shoot damage caused by the inoculation of the bacterial strains or an elevated arsenic concentration. Metals can affect the water mobility in plants by disturbing processes such as root development and evaporation from the leaves (Rucińska-Sobkowiak 2016). This dead plant material was not included in the measurement of the shoot length, but included in the fresh weight. Inoculated plants have a tendency towards a higher number of roots, fresh weight and root length (Fig. 2).
NMDS ordination plot of the different Oryza sativa plant groups (with their centroid) without arsenic nor bacterial strain (group 1), with 25 µM arsenite without bacterial strain (group 2), inoculated strain As5 without arsenite (group 3), inoculated with strain As5 and with arsenite (group 4), an elevated concentration of 40 µM of arsenite and strain As5 (group 5) and a concentration of 20 µM arsenite and type strain SCII24 (group 6). Stress = 0.056
A global analysis showed a positive relation of 2.2% total arsenic uptake increase per 10 mg of plant fresh weight and 1.5% arsenic uptake increase per centimetre growth (ART; p = 0.021; p = 0.002) and was taken as a covariate in the analysis of the relation between treatment group and plant arsenic uptake.
Arsenic distribution between root and shoot
The distribution of the arsenic between the aboveground part (shoot) and belowground part (root) of the pooled rice plants was similar between the groups, with 5.1% ± 1.3% (95% confidence interval) of the arsenic in the plant tissue being present in the aboveground part. Although small, the trend of arsenic in the shoot among treatment groups did not suggest to be different from the root tissue, with the highest arsenic uptake without inoculated bacterial strain: 9.91 µg ± 3.8 µg (95% confidence interval) in root and 0.41 µg ± 0.09 µg in shoot. The lowest arsenic uptake by the plants was found in presence of the hyperacumulator strain: 5.43 µg ± 2 µg in the root and 0.32 µg ± 0.2 µg in the shoot. The plants inoculated with the type strain SCII24 showed an uptake of 6.76 µg ± 1.6 µg in the root and a 0.36 µg ± 0.17 µg in the shoot. There was a significant difference in arsenic content between the plants with 25 µM sodium arsenite and the plants with 25 µM sodium arsenite and inoculation of the modified strain As5 (ANOVA and Tukey post-hoc test; p < 0.05).
Relation between arsenic uptake and treatment
When considered individually, experiment 1 and 2 showed similar trends in the arsenic uptake (µg arsenic in plant/µg total arsenic) among groups. In experiment 1, amounts of arsenic per fresh weight were 191.04 ± 31.41 µg/g fresh weight, for the group with only 25 µM arsenic (group 2); 72.82 ± 23.71 µg/g fresh weight for plants with 25 µM arsenic and inoculation of strain O. tritici As5 (group 4) and 83.63 ± 21.58 µg/g fresh weight for plants with 40 µM arsenic and inoculation of strain O. tritici As5 (group 5). For experiment 2, the groups 2, 4 and the group with 25 µM arsenic and inoculation of type strain O. tritici SCII24 (group 6) had the following values: 139.65 ± 17.16 µg/g fresh weight, 76.10 ± 25.26 µg/g fresh weight and 94.43 ± 16.55 µg/g fresh weight.
When the arsenic uptake (µg arsenic in plant/µg total arsenic) of both experiments are taken together, the group 2, that contains the plants with 25 µM arsenic only, showed the highest total arsenic uptake: 76.5% ± 10.5% (confidence interval of 95%). The second group that exhibited the highest amount of arsenic uptake was group 6 with 25 µM arsenic and inoculation of strain O. tritici SCII24: 47.4% ± 13.4% taken up. Then group 4 with 25 µM arsenic and inoculation of O. tritici As5 followed with an arsenic uptake of 30% ± 6%. Finally, the group 5 with a concentration of 40 µM arsenite and inoculation of O. tritici As5 showed the lowest arsenic uptake of 21% ± 6% (Fig. 3).
The fraction of arsenic taken up from the medium (µg/total µg) per plant treatment group errorbars are standard errors. The symbol * indicates that this plant treatment group (of both experiments) was significantly different from all other treatment groups, taking into account fresh weight covariance (p < 0.05; ANCOVA)
In experiment 1, when plants were grown in absence of bacteria inoculation, the fraction of arsenic uptake was 3.55 fold higher, while in experiment 2, the arsenic fraction in control group was 1.7 fold higher than groups in absence of the both strains (type strain or O. tritici As5), taking into account the increase in arsenic uptake due to fresh weight and shoot growth (ANCOVA; p < 0.001 in experiment 1; p = 0.0087 in experiment 2).
Comparing the inoculated plants with type strain SCII24 and with modified strain As5, the plants in the two groups with the modified strain had a lower uptake than the type strain (Dunnett’s test; p < 0.001). When the fresh weight and shoot growth were included as covariates, the plant arsenic uptake was still higher in the type strain SCII24 inoculated groups (ANCOVA; p < 0.05).
Discussion
Symbiotic plant–bacteria associations can modify metal tolerance and its bioaccumulation in plants and the alternative strategy of using microbes to enhance metal tolerance in plants has recently gained importance (Tiwari and Lata 2018). Bacterial strains of agronomic importance that have been used in the protection of crops, reduce heavy metal uptake by the following mechanisms: absorption and accumulation on the cell walls, transport over the cytoplasmic membrane, entrapment of metals by capsules outside of the cell, detoxification by redox reactions and precipitation of the metals (Tiwari and Lata, 2018). In this study, the strain O. tritici revealed a significant impact on the plant metal uptake, via the transport of arsenic over the cytoplasmic membrane. More specifically, the plant treatment with the hyperaccumulator strain As5 showed a lower plant arsenic uptake than inoculation with the non-modified strain (O. tritici SCII24). The accumulation of arsenic by the (rhizo)bacteria removes arsenic ions that may otherwise end up accessible to the rice plant’s root tissue. By our knowledge, this is the first study that zoomed in on the contribution of bacterial metal accumulation on metal concentration of plant tissues. A previous study found that the toxic effects of nickel and cadmium were lower for tomato plants inoculated with endophytic bacteria than without bacterial inoculants (Madhaiyan et al. 2007). The nickel and cadmium concentrations in the plant tissue, root and shoot, were lower in the presence of the PGPB, strain Burkholderia sp. CBMB40 and strain Methylobacterium oryzae CBMB20 (Madhaiyan et al. 2007). Another study used a cadmium resistant strain Ochrobactrum sp. CdSP9 and some of the toxic effects of cadmium on the rice plants were eleviated when this strain was inoculated (Pandey et al. 2013). The inoculation of strain CdSP9 in presence of cadmium lead to a decreased concentration of superoxide dismutase in the plant tissue (Pandey et al. 2013). This strain Ochrobactrum sp. showed 1-aminocyclopropane-1-carboxylate (ACC) deaminase activity and siderophore producing ability (Pandey et al. 2013).
Both, addition of arsenic or either of the strains O. tritici As5 or O.tritici SCII24 negatively affected the growth, but no added negative effect was observed in treatment with both arsenic and a bacterial strain (Fig. 4). A study of inoculated rice plants with the strain Bacillus aryabhattai AS6 led to an alleviation of the toxicity of arsenic in rice plants (Ghosh et al. 2018). Similarly, the current study found a reduced arsenic uptake and a reduced arsenic toxicity on plant length when the hyperaccumulator strain was inoculated, compared to the results of plants inocculated with unmodified type strain.
In contrast to the studies that found a reduction in plant metal uptake by inoculation of a bacterial strain, Mesa and coworkers 2017 found an increase arsenic concentration in the roots of Betula celtiberica in the presence of the rhizosphere bacterial strains that they isolated earlier from the root rhizosphere. Additionally, they found an increased plant growth with the presence of endophyte strains.
The reduction of arsenic toxicity in plants can be explained by direct effects of the microbes, such as the accumulation of ions by the (rhizo)bacteria and indirect effects. Indirect effects of microbes on plant and metal interactions include the production of siderophores and plant growth promoting hormones (Ghosh et al. 2018), the solubilization of phosphates and the production of organic acids (Mesa et al. 2017), the formation of a biofilm and the production of exopolysaccharides (Tiwari and Lata 2018). In the outer layer of the rice plant, the formation of an “iron plaque”, interspersed with arsenate, was found in a previous study by Seyfferth et al. (2010). This “iron plaque” possibly reduces the amount of arsenic in the root tissue. The iron plaque is not likely to have played a role in the arsenic resistance in our study since this plaque mainly occurs on older roots and probably due to oxidation by oxygen from the atmosphere diffusing into the soil (Seyfferth et al. 2010).
Since we are studying the interactions between rice plants, bacterial cells of O. tritici and arsenite (Fig. 4), the individual effects between the elements should be considered as well. The effects of arsenite on the bacterial strain, at the concentrations used, are expected to be minimal, since a previous study found that the strain SCII24 was able to grow up to arsenite concentrations of 50 mM and the modified strain As5 could grow in concentrations of up to 1 mM (Sousa et al. 2015). Considering the fact that both, the inoculation of the bacterial strain and the presence of the arsenite, negatively impacted the growth parameters of the plant, it would be expected that in presence of both, the bacterial inoculation and the arsenite, there would be an additive effect or, at least, a stronger negative effect. Instead, the plant parameters did not significantly differ between the group with just the presence of arsenic or bacterial strain (inoculation of the bacterial strain) and the group with both effects (arsenite and bacterial inoculation; Fig. 4). In experiment 1 the rice plants with the strain O. tritici As5 even grew better (increased shoot growth), when there was arsenic in the medium (p < 0.05), suggesting that certain bacterial strains, due to specific metabolic characteristics, may be more beneficial to plants in the presence of the metal than without. This was also noticed in the study by Francisco et al. (2018), where O. sativa varieties were inoculated with O. tritici and subjected to Cr(VI) contamination. Similarly, the strain O. tritici affected growth parameters of the rice plants, and a better plant development was observed in inoculated plants subjected to low Cr(VI) contamination when compared to plants inoculated but not subjected to Cr(VI), and plants only subjected to Cr(VI).
The inoculation of O. tritici As5 and type strain SCII24 lead to a reduction in arsenic uptake by rice plants, but the inoculation of the hyperaccumulator O. tritici As5 resulted in an even smaller arsenic uptake in the rice plants. The difference in plant arsenic uptake when inoculated with the two different strains, strongly suggests that accumulation of metals by the bacterial strains, play an important role in metal tolerance induction by rhizobacteria, but inoculation of the type strain O. tritici,,with a functional arsenite efflux pump, did also lead to a reduced arsenic uptake.
In conclusion, inoculation of the hyperaccumulator strain As5 reduces the uptake of arsenic by the rice plants and alleviaties some of the toxic effects of arsenic on shoot length, compared to inoculation of the type strain SCII24. The rice plants were found to be negatively affected by both bacterial inoculation and arsenic presence. However, when O. tritici As5 was inoculated, the total negative effect on plant length and weight was reduced when arsenic was present in the medium. We succesfully inoculated the modified strain O. tritici As5 onto the rice plants and, thereby, developed a bacterium–plant conjoint with a reduced arsenic uptake. Additionally, rhizobacteria such as O. tritici could find a use in the deployment of the plant–bacterium association as a phytostabilizer, keeping the arsenic in the bacterial cells in the rhizosphere.
References
Alcantara-Martinez N, Figueroa-Martinez F, Rivera-Cabrera F, Gutierrez-Sanchez G, Volke-Sepulveda T (2018) An endophytic strain of Methylobacterium sp. increases arsenate tolerance in Acacia farnesiana (L.) Willd: a proteomic approach. Sci Total Environ 625:762–774
Bilal S, Shahzad R, Khan AL, Kang SM, Imran QM, Al-Harrasi A et al (2018) Endophytic microbial consortia of phytohormones-producing fungus Paecilomyces formosus LHL10 and bacteria Sphingomonas sp. LK11 to Glycine max L. regulates physio-hormonal changes to attenuate aluminum and zinc stresses. Front Plant Sci 9:1273
Bowman AW, Azzalini A (2018) R package ‘sm’: nonparametric smoothing methods (version 2.2–5.6). http://www.stats.gla.ac.uk/~adrian/sm
Branco R, Chung AP, Morais PV (2008) Sequencing and expression of two arsenic resistance operons with different functions in the highly arsenic-resistant strain Ochrobactrum tritici SCII24 T. BMC Microbiol 8:95
Branco R, Sousa T, Piedade AP, Morais PV (2016) Immobilization of Ochrobactrum tritici As5 on PTFE thin films for arsenite biofiltration. Chemosphere 146:330–337
Briat JF (2010) Arsenic tolerance in plants: “Pas de deux” between phytochelatin synthesis and ABCC vacuolar transporters. Proc Natl Acad Sci USA 107:20853–20854
Dell’Amico E, Cavalca L, Andreoni V (2005) Analysis of rhizobacterial communities in perennial Graminaceae from polluted water meadow soil, and screening of metal-resistant, potentially plant growth-promoting bacteria. FEMS Microbiol Ecol 52:153–162
Flanagan SV, Johnston RB, Zheng Y (2012) Arsenic in tube well water in Bangladesh: health and economic impacts and implications for arsenic mitigation. Bull World Health Organ 90:839–846
Fraga H, Guimarães N, Santos JA (2019) Future changes in rice bioclimatic growing conditions in Portugal. Agronomy 9:674
Francisco R, de Abreu P, Plantz BA, Schlegel VL, Carvalho RA, Morais PV (2011) Metal-induced phosphate extracellular nanoparticulate formation in Ochrobactrum tritici 5bvl1. J Hazard Mater 198:31–39
Francisco R, Branco R, Schwab S, Baldani JI, Morais PV (2018) Impact of plant-associated bacteria biosensors on plant growth in the presence of hexavalent chromium. World J Microb Biot 34:12
Ghosh PK, Maiti TK, Pramanik K, Ghosh SK, Mitra S, De TK (2018) The role of arsenic resistant Bacillus aryabhattai MCC3374 in promotion of rice seedlings growth and alleviation of arsenic phytotoxicity. Chemosphere 211:407–419
Hoagland DR, Arnon DI (1950) The water-culture method for growing plants without soil. Circular 347 (California agricultural experiment station)
Hurek T, Reinhold-Hurek B, Van Montagu M, Kellenberger E (1994) Root colonization and systemic spreading of Azoarcus sp. strain BH72 in grasses. J Bacteriol 176:1913–1923
Kofroňová M, Mašková P, Lipavská H (2018) Two facets of world arsenic problem solution: crop poisoning restriction and enforcement of phytoremediation. Planta 48:19–35
Lenth R (2019) emmeans: estimated marginal means, aka least-squares means. R package version 1.4.2. https://CRAN.R-project.org/package=emmeans
Ma Y, Prasad MNV, Rajkumar M, Freitas H (2011) Plant growth promoting rhizobacteria and endophytes accelerate phytoremediation of metalliferous soils. Biotechnol Adv 29:248–258
Madhaiyan M, Poonguzhali S, Sa T (2007) Metal tolerating methylotrophic bacteria reduces nickel and cadmium toxicity and promotes plant growth of tomato (Lycopersicon esculentum L.). Chemosphere 69:220–228
Mandal BK, Suzuki KT (2002) Arsenic round the world: a review. Talanta 58:201–235
Mesa V, Navazas A, González-Gil R, González A, Weyens N, Lauga B, Peláez AI (2017) Use of endophytic and rhizosphere bacteria to improve phytoremediation of arsenic-contaminated industrial soils by autochthonous Betula celtiberica. Appl Environ Microbiol 83:e03411–e3416
Oksanen J, Blanchet FG, Friendly M, Kindt R, Legendre P, McGlinn D et al (2018) Vegan: community ecology package. R package version 2.5-2. https://CRAN.R-project.org/package=vegan
Pandey S, Ghosh PK, Ghosh S, De TK, Maiti TK (2013) Role of heavy metal resistant Ochrobactrum sp. and Bacillus spp. strains in bioremediation of a rice cultivar and their PGPR like activities. J Microbiol 51:11–17
R Core Team (2018) R: a language and environment for statistical computing. R Foundation for Statistical Computing, Vienna, Austria. https://www.R-project.org/
Rucińska-Sobkowiak R (2016) Water relations in plants subjected to heavy metal stresses. Acta Physiol Plant 38(11):257
Seyfferth AL, Webb SM, Andrews JC, Fendorf S (2010) Arsenic localization, speciation, and co-occurrence with iron on rice (Oryza sativa L.) roots having variable Fe coatings. Environ Sci Techol 44:8108–8113
Shahabivand S, Parvaneh A, Aliloo AA (2017) Root endophytic fungus Piriformospora indica affected growth, cadmium partitioning and chlorophyll fluorescence of sunflower under cadmium toxicity. Ecotox Environ Saf 145:496–502
Sousa T, Branco R, Piedade AP, Morais PV (2015) Hyper accumulation of arsenic in mutants of Ochrobactrum tritici silenced for arsenite efflux pumps. PLoS ONE 10:e0131317
Tiwari S, Lata C (2018) Heavy metal stress, signaling, and tolerance due to plant-associated microbes: an overview. Front Plant Sci 9:452
Tsai SL, Singh S, Chen W (2009) Arsenic metabolism by microbes in nature and the impact on arsenic remediation. Curr Opin Biotech 20:659–667
Villacorta PJ (2015) ART: Aligned Rank Transform for nonparametric factorial analysis. R package version 1.0. https://CRAN.R-project.org/package=ART
Wickham H (2016) ggplot2: elegant graphics for data analysis. Springer, New York
Zhao FJ, McGrath SP, Meharg AA (2010) Arsenic as a food chain contaminant: mechanisms of plant uptake and metabolism and mitigation strategies. Annu Rev Plant Biol 61:535–559
Zhuang X, Chen J, Shim H, Bai Z (2007) New advances in plant growth-promoting rhizobacteria for bioremediation. Environ Int 33:406–413
Acknowledgements
This work was supported by CEMMPRE and by Fundação para a Ciência e a Tecnologia (FCT) under the project UID/EMS/00285/2013 and the project ERA-MIN/0002/2015. MM was supported by the ERA-MIN/0002/2015 project through a research fellowship. RB was supported by a FCT Grant SFRH/BPD/110807/2015. We thank Romeu Francisco for critical reading of the manuscript.
Author information
Authors and Affiliations
Corresponding author
Additional information
Publisher's Note
Springer Nature remains neutral with regard to jurisdictional claims in published maps and institutional affiliations.
Electronic supplementary material
Below is the link to the electronic supplementary material.
Rights and permissions
About this article
Cite this article
Moens, M., Branco, R. & Morais, P.V. Arsenic accumulation by a rhizosphere bacterial strain Ochrobactrum tritici reduces rice plant arsenic levels. World J Microbiol Biotechnol 36, 23 (2020). https://doi.org/10.1007/s11274-020-2800-0
Received:
Accepted:
Published:
DOI: https://doi.org/10.1007/s11274-020-2800-0